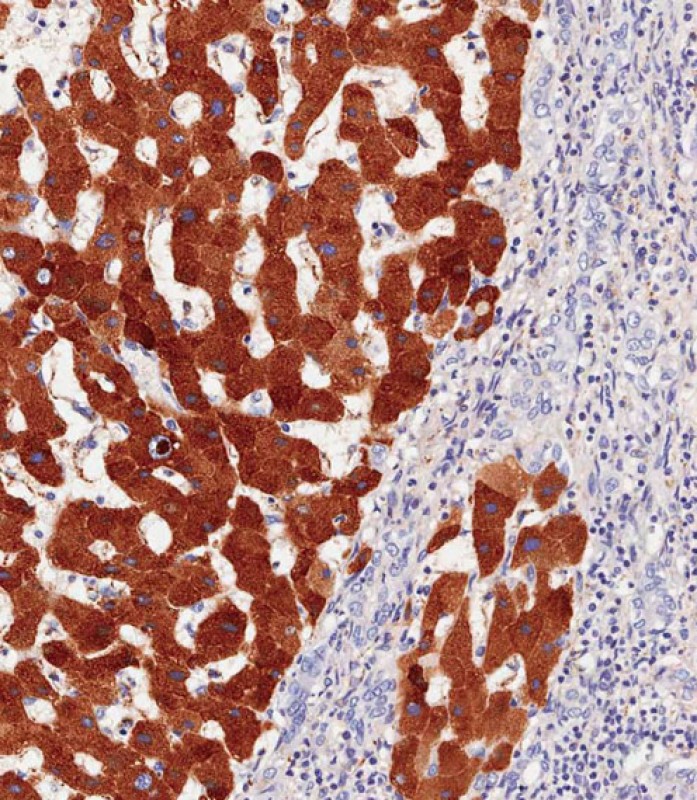

-
分类: 科研抗体货号: P34734别名: Cyclin-Y, Cyc-Y, Cyclin box protein 1, Cyclin fold protein 1, cyclin-X, CCNY, C10orf9, CBCP1, CFP1应用: WB,IHC反应种属: Human, Mouse
-
分类: 科研抗体货号: P34735别名: Haptoglobin, Zonulin, Haptoglobin alpha chain, Haptoglobin beta chain, HP应用: WB,IHC反应种属: Human, Mouse, Rat
-
分类: 科研抗体货号: P34733别名: Lysosomal-associated transmembrane protein 5, Lysosomal-associated multitransmembrane protein 5, Retinoic acid-inducible E3 protein, LAPTM5, KIAA0085应用: WB反应种属: Human
-
分类: 科研抗体货号: P34749别名: Diacylglycerol kinase kappa, DAG kinase kappa, 142 kDa diacylglycerol kinase, Diglyceride kinase kappa, DGK-kappa, DGKK应用: WB反应种属: Human
-
分类: 科研抗体货号: P34759别名: Regulatory-associated protein of mTOR, Raptor, p150 target of rapamycin (TOR)-scaffold protein, RPTOR, KIAA1303, RAPTOR应用: WB,IHC反应种属: Human, Mouse, Rat
-
分类: 科研抗体货号: P34747别名: T-lymphoma invasion and metastasis-inducing protein 1, TIAM-1, TIAM1应用: WB反应种属: Human, Mouse, Rat
-
分类: 科研抗体货号: P34758别名: Selenoprotein K, SelK, SELK应用: WB反应种属: Human, Mouse, Rat
-
分类: 科研抗体货号: P34746别名: F-box/LRR-repeat protein 19, F-box and leucine-rich repeat protein 19, FBXL19, FBL19应用: WB反应种属: Human, Mouse
-
分类: 科研抗体货号: P34757别名: Corticosteroid-binding globulin, CBG, Serpin A6, Transcortin, SERPINA6, CBG应用: WB,IHC反应种属: Human
-
分类: 科研抗体货号: P34745别名: OTU domain-containing protein 7A, Zinc finger protein Cezanne 2, OTUD7A, C15orf16, CEZANNE2, OTUD7应用: WB反应种属: Human, Mouse

鄂公网安备42018502007531号
鄂公网安备42018502007531号

